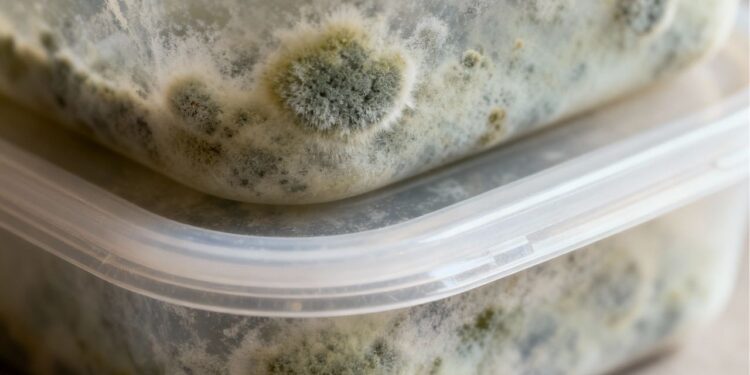
Mofo em potes plásticos? Aprenda como evitar de vez

O mofo em potes plásticos é um problema comum em muitas cozinhas. Ele surge pela combinação de umidade e falta de ventilação.
A boa notícia é que existem formas simples e eficazes de evitar que isso aconteça. Com cuidados práticos, você mantém seus recipientes limpos e seguros.
Por que o mofo aparece nos potes plásticos da cozinha?
O mofo se forma em ambientes fechados, escuros e úmidos, condições que potes plásticos mal secos costumam oferecer.
Além de causar mau cheiro, ele pode comprometer a durabilidade do recipiente e até afetar a saúde.
“A umidade acumulada em recipientes plásticos cria um ambiente propício para a proliferação de fungos”, afirma Centers for Disease Control and Prevention (CDC), conforme CDC. Cleaning and Disinfecting Your Home. Atlanta: CDC, 2024. p. 6. URL. Acesso em: 29 set. 2025.

Secagem completa evita umidade acumulada
O primeiro passo para prevenir o mofo é garantir que os potes estejam completamente secos antes de guardar.
- Deixe os recipientes abertos sobre um pano limpo após a lavagem
- Use papel toalha para remover a umidade das tampas
- Evite empilhar potes ainda úmidos
Essa prática simples reduz drasticamente a chance de formação de fungos e garante maior durabilidade dos recipientes.
Ventilação nos armários ajuda na conservação
Guardar os potes em armários bem ventilados também faz diferença. O ar circulando reduz a umidade interna.
- Deixe espaços entre os recipientes dentro do armário
- Instale pequenas grelhas ou use móveis com aberturas
- Abra as portas dos armários periodicamente
A circulação de ar constante impede que a umidade se acumule, dificultando o aparecimento de mofo.
Uso do bicarbonato elimina odores e fungos
Outra solução eficaz é o uso do bicarbonato de sódio, conhecido por neutralizar cheiros e absorver umidade.
- Coloque uma colher de bicarbonato dentro do pote seco
- Use sachês de bicarbonato nos armários de cozinha
- Lave os recipientes regularmente com água e bicarbonato
Esse recurso simples é barato e funciona como um aliado contra o mofo em potes plásticos.
“O bicarbonato de sódio é um agente seguro e eficaz para controlar odores e fungos em ambientes internos”, destaca Environmental Protection Agency (EPA), conforme EPA. A Brief Guide to Mold, Moisture and Your Home. Washington: EPA, 2023. p. 4. URL. Acesso em: 29 set. 2025.

Quais hábitos mantêm os potes sempre livres de mofo?
Manter potes plásticos em bom estado exige hábitos consistentes na rotina de limpeza e armazenamento.
- Lavar e secar bem após cada uso
- Guardar sempre com a tampa aberta ou semiaberta
- Evitar guardar alimentos úmidos por muito tempo
Com essas práticas, você garante potes sempre prontos para uso e uma cozinha mais saudável.
Perguntas Frequentes
É seguro usar potes que já tiveram mofo?
Não é recomendado. Mesmo após a limpeza, resíduos podem permanecer nos poros do plástico, representando risco à saúde.
Qual produto de limpeza é mais indicado para remover mofo?
O bicarbonato de sódio é uma opção segura, mas em casos persistentes a água sanitária diluída pode ser usada, sempre com enxágue completo.
Guardar potes na geladeira aumenta o risco de mofo?
Não. Na geladeira, o risco é menor, mas é importante não guardar recipientes úmidos, pois a umidade pode favorecer fungos em alguns casos.
Cuidar dos potes plásticos com pequenas ações diárias garante mais higiene, durabilidade e segurança no armazenamento dos alimentos.